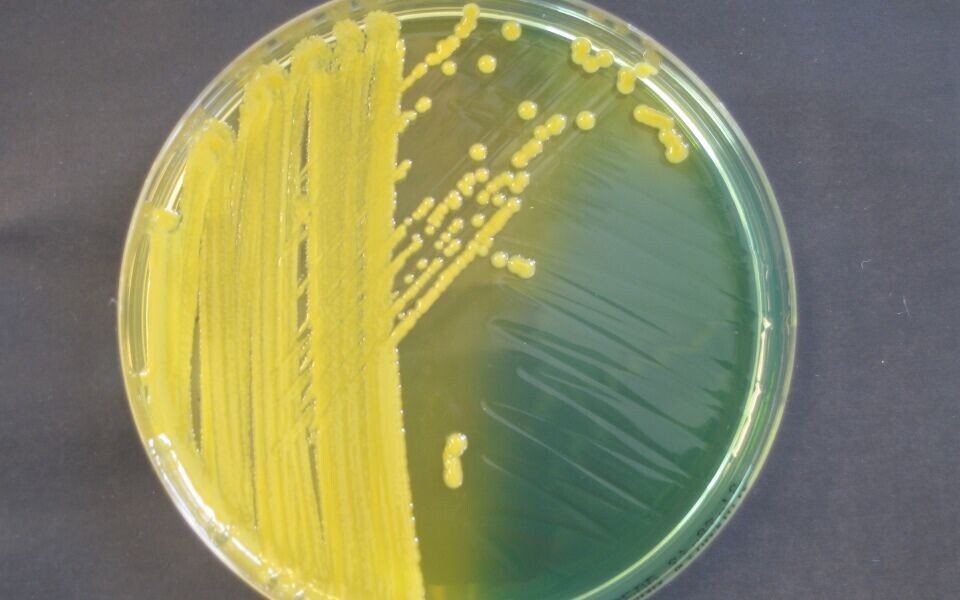

FAG Aktuelt
Ublidt møte med NDM-1
Den reiseglade pensjonisten Lill-Karin Skaret (67) kom våren 2010 hjem fra India som intetanende bærer av NDM-1 positiv Klebsiella pneumoniae. Det ble starten på måneder preget av frykt og usikkerhet for Skaret og familien.
Lill-Karin Skaret hadde vært i India flere ganger tidligere da hun satte seg på flyet i begynnelsen av mars for snart to år siden. Men denne gangen fikk ferien en brå slutt – hun havnet i en trafikkulykke like etter ankomst.
- Jeg ble kjørt til et sykehus, hvor jeg til å begynne med ble liggende i et rom med kanskje 30 – 40 andre pasienter. Det var veldig varmt og hygienen var svært dårlig, forteller hun.

Etter hvert fikk Skaret enerom og det ble tatt røntgenbilde av henne.
- Jeg ble fortalt at den kunstige hoften min hadde løsnet og at lårbeinet var brukket. De var nødt til å operere.
Først i månedsskiftet mars/april fikk hun reise hjem til Norge. Der ble hun lagt på isolat på lokalsykehuset.
- Det ble tatt prøver av meg, og de var negative for MRSA. Etter cirka en uke ble jeg sendt hjem, forteller Skaret.
”Spedalsk”
Men det skulle vise seg at hun hadde fått med seg en annen resistent mikrobe fra sykehusoppholdet i India. Cirka 14 dager etter at hun var utskrevet, ringte telefonen:
- Legen sa at jeg hadde Klebsiella med NDM-1. Jeg hadde hatt barnebarnet mitt på besøk, og vi ble livredde for smitte, forteller hun.
Skaret fikk ikke noen infeksjon, men hun var bærer av den resistente bakterien. Stammen som ble isolert fra henne, var faktisk det andre tilfellet av NDM-1 som ble identifisert i Norge. Det første var blitt påvist noen måneder tidligere.
2010 var også året da til dels svært feilaktige oppslag om ”den nye superbakterien NDM-1” florerte i media. Skaret og familien savnet informasjon, og de ble ikke akkurat beroliget av det de leste seg til på egen hånd.
- Folk var redde for å ha kontakt med meg. Jeg følte meg nærmest spedalsk, sier hun.
Beroliget
I jakten på informasjon kom familien etter hvert i kontakt med Arnfinn Sundsfjord på K-res. Han kunne berolige dem med at bakterien nok ville forsvinne av seg selv etter hvert. Det var akkurat det som skjedde.
- Jeg tok prøver hver måned. I oktober samme år hadde jeg hatt tre negative prøver på rad, og kunne anses som ikke smittebærende, forteller Skaret.